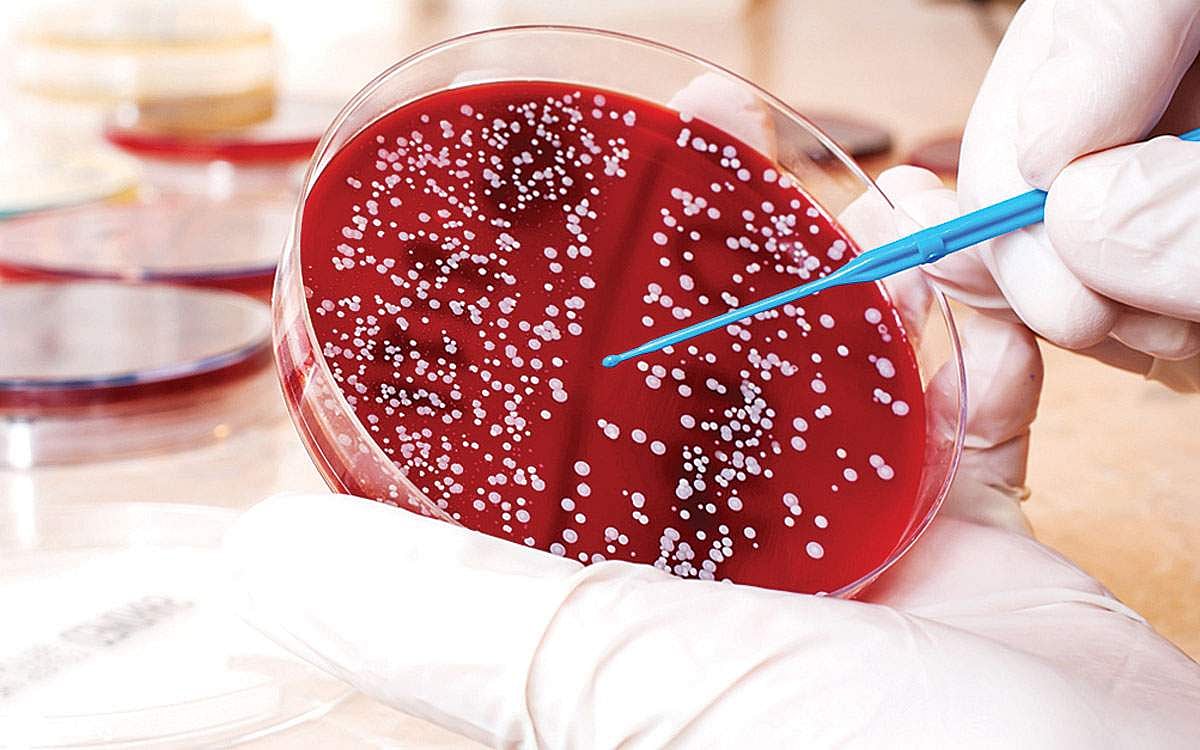
News image

ரத்தத்தின் ரத்தமே... - 27
"கோச்சடையான்' திரைப்படப் பாடல் வரிகளைப் போல உலகெங்கிலும் எல்லாமே ஒவ்வொரு விநாடியும் மாறிக்கொண்டேதான் இருக்கிறது.

"மாற்றம் ஒன்றுதான் மாறாதது
மாறுவதெல்லாம் உயிரோடு
மாறாததெல்லாம் மண்ணோடு'
என்ற கவிப்பேரரசு வைரமுத்து "கோச்சடையான்' திரைப்படப் பாடல் வரிகளைப் போல உலகெங்கிலும் எல்லாமே ஒவ்வொரு விநாடியும் மாறிக்கொண்டேதான் இருக்கிறது. பழையன கழிதலும் புதியன புகுதலும் என்ற சொல் எங்கும் எதிலும் நடந்து கொண்டேதான் இருக்கிறது. மனித உடலும் இதேபோல் ஒவ்வொரு விநாடியும் மாறிக்கொண்டே தான் இருக்கிறது. நமது உடலிலுள்ள திசுக்கள் சிதைந்தாலோ, சேதமடைந்தாலோ, பாதிக்கப்பட்டாலோ அல்லது வயதானாலோ, அவை பொதுவாக இறந்துவிடுவதுண்டு. இறந்த திசுக்களுக்குப் பதிலாக புதிய திசுக்கள் வருவதுண்டு. வளர்வதுண்டு. இவ்வாறு உடலில் தொடர்ந்து வளர்சிதை மாற்றங்கள் நடந்துகொண்டே தான் இருக்கின்றது.
ஆனால் சில சமயங்களில் இவ்வாறு பழையன கழிதலும் புதியன புகுதலும் நடக்காமல் நின்றுவிடும். பழைய திசுக்கள் பாழாகி உடலைவிட்டு வெளியே போகாமல் அது மறுபடியும் வேறு உருவெடுத்து வளர ஆரம்பித்துப் பல மடங்கு பெருகி உருண்டு திரண்டு ஒரு கட்டியாக (ட்யூமர்) உருவாகிவிடுகிறது. இந்தக் கட்டி சாதாரணக் கட்டியாகவும் அப்படியே இருக்கலாம். சில நேரங்களில் பின்னாளில் இதுவே புற்றுநோய்க் கட்டியாகவும் மாறலாம்.
உலகில் சுமார் 120-க்கும் மேல் புற்றுநோய் வகைகள் இருப்பதாகச் சொல்லப்படுகிறது. ஆனால் நாம் அடிக்கடி அதிகமாகக் கேள்விப்படுவது மிகக் குறைவான சில வகை புற்றுநோய்களே
1) சிறுநீரகப் பை புற்றுநோய் 2) மார்பக புற்றுநோய் 3)பெருங்குடல்-ஆசனவாய்ப் பகுதி புற்றுநோய் 4) சிறுநீரகப் புற்றுநோய்5) நுரையீரல் புற்றுநோய்6) கருங்கட்டி (மெலனோமா) 7) வாய் மற்றும் தொண்டை புற்றுநோய் 8)கணையப் புற்றுநோய்9) ப்ராஸ்டேட் சுரப்பிப் புற்றுநோய்10) தைராய்டு சுரப்பிப் புற்றுநோய் 11) கர்ப்பப்பை புற்றுநோய் 12) எலும்பு புற்றுநோய் 13) மூளை புற்றுநோய் 14) இரைப்பைப் புற்றுநோய்15) கர்ப்பப்பை வாய் புற்றுநோய் மொத்தப் புற்றுநோய்களிலேயே கணையப் புற்றுநோய்தான் மிகமிகக் கொடுமையானது. இதைக் கண்டுபிடிப்பதும் சிரமம். வெகு சீக்கிரம் ஆரம்பித்து வெகு சீக்கிரத்தில் ஆளைக் கொன்றுவிடும். இடைப்பட்ட வேளையில் நரகவேதனை என்று சொல்வார்களே அதை உண்டு பண்ணிவிடும். சித்திரவதைகள் எத்தனை வகை உண்டோ அத்தனையையும் நோயாளிக்கு செய்து விடும். மார்பகம் ப்ராஸ்டேட் சுரப்பி, ஆண் விந்தணு, விதைகள், தோல், தைராய்டு, கர்ப்பப்பை, வாய் முதலிய இடங்களில் ஏற்படும் புற்றுநோய்களை ஆரம்பத்திலேயே கண்டுபிடித்துவிட்டால் உடனடியாக சிகிச்சை அளித்துக் கண்டிப்பாக நூறு சதவீதம் குணப்படுத்திவிடலாம்.
பெண்களைப் பொருத்தவரை மற்ற புற்றுநோய்களைவிட மார்பகப் புற்றுநோயும் கர்ப்பப்பை புற்றுநோயும் தான் மிக அதிகமாக ஏற்படுகிறது. உடலில் புற்றுநோய் இருக்கிறது என்று 8 பெண்கள் வந்தால் அதில் ஒரு பெண்ணுக்கு கண்டிப்பாக மார்பக புற்றுநோய் இருக்கிறது. இரண்டு மார்பகங்களில் ஏதாவதொன்றில் முதலில் ஒரு சிறிய உருண்டைக் கட்டியாக உருவாகி பின் பெரிதாகி பின் மார்பகத்திலிருந்து ரத்தக் குழாய்கள் மூலமாகவும் நிணநீர்க் குழாய்கள் வழியாகவும் வெளியேறி உடலின் மற்ற பாகங்களில் போய் உட்கார்ந்து கொண்டு பரவ ஆரம்பித்துவிடுகிறது.
புற்றுநோய் எலும்பில் பரவ ஆரம்பித்தால் எலும்பு வலியும் எலும்பு முறிவும் ஏற்படும் புற்றுநோய் மூளையில் பரவ ஆரம்பித்தால் தலைவலி, வலிப்பு, வாந்தி, மயக்கம், தலைசுற்றல் ஏற்படும். புற்றுநோய் நூரையீரலில் பரவ ஆரம்பித்தால், அதிக இருமல் சுவாசக் கோளாறு, மூச்சுவிடப் பிரச்னை, வயிறு வீக்கம், சிறுநீர் மஞ்சள் நிறத்தில் போதல் ஏற்படும். புற்றுநோய் இரைப்பையில் பரவ ஆரம்பித்தால், பசியின்மை, ஏப்பம், வயிற்றுவலி, ரத்தவாந்தி ஏற்படும்.
புற்றுநோய் வகைகளிலேயே ரத்த புற்றுநோய் என்று சொன்னால் எல்லோருக்கும் தெரியும். ஏனென்றால் திரைப்படங்களில் அதிகமாகக் காட்டப்படுவது ரத்த புற்றுநோயாளியைத் தான். ரத்த புற்றுநோயை "லுக்கீமியா' என்றும் ரத்தப் புற்றுநோய் என்றும் அழைப்பதுண்டு. ரத்தப் புற்றுநோய் என்பது ரத்தத்திலும் எலும்பு மஜ்ஜையிலும் இருப்பதாகும். நல்ல செல்கள் இருக்கவேண்டிய ரத்தத்தில் தீய செல்கள் எல்லையில்லா அளவில் இருப்பதே ரத்தப் புற்றுநோயாகும். இந்தத் தீய செல்களின் வளர்ச்சி நமது உடல் எலும்புகளின் நடுவிலுள்ள எலும்பு மஜ்ஜையில் தான் உருவாகிறது.
கண் மூடி கண் திறப்பதற்குள் இந்தத் தீய செல்களின் வளர்ச்சி கட்டுக்கடங்காமல் பெருகிவிடுகிறது. எலும்பு மஜ்ஜையில் அசுர வேகத்தில் உருவாகும் இந்தத் தீய செல்கள் அனைத்தும் ரத்த ஓட்டத்தில் கொட்டப்பட்டு ரத்தத்தில் கலந்துவிடுகிறது.
பொதுவாக ஒருவருக்கு புற்றுநோய் வந்திருக்கிறது என்றால் நோய் ஏற்பட்டிருக்கும் இடத்தில் ஒரு கட்டியாகவோ ஒரு வீக்கமாகவோ ஒரு புண்ணாகவோ காட்டும். இதை வைத்து புற்றுநோய்க்கட்டி எவ்வளவு பெரிதாக
இருக்கிறது. எவ்வளவு வேகமாக வளருகிறது என்பதையெல்லாம் கண்டுபிடித்துவிடலாம்.
ஆனால் ரத்தப் புற்றுநோயைப் பொருத்தவரை ஒரு கட்டியாகவோ ஒரு வீக்கமாகவோ ஒரு புண்ணாகவோ இருக்காது. ஏனெனில் ரத்தப் புற்றுநோய்க்கு உருவம் கிடையாது. தீய சக்தியாகிய ரத்தப் புற்றுநோய் செல்கள் அதிக அளவில் உருவாகி ரத்த ஓட்டத்தில் கலந்து ஓடிக்கொண்டிருப்பதால் இதைக் கண்டுபிடிப்பது கடினம். எக்ஸ்ரே, ஸ்கேன் போன்ற பரிசோதனைகளிலும் கூட இது தெரியாது.
ரத்தப் புற்றுநோயில் கூட பல வகைகள் இருக்கின்றன. சில ரத்தப் புற்றுநோய்கள் குழந்தைகளிடம் அதிகமாக இருக்கும். சில ரத்தப் புற்றுநோய்கள் பெரியவர்களிடம் அதிகமாக இருக்கும். ரத்தப் புற்றுநோய்க்குச் சிகிச்சைக்குக் கூட அது எந்த வகையைப் பொருத்தது என்பதை வைத்துதான் முடிவு செய்ய முடியும்.
ரத்தப் புற்றுநோய் ஒருவருக்கு இருக்கிறதா என்பதை முதலில் சில அறிகுறிகளை வைத்தும் பின்னர் ரத்தப் பரிசோதனையை வைத்தும் முடிவு பண்ணலாம். ரத்தப் புற்றுநோயினால் பாதிக்கப்பட்டவர்கள் முதலில் எந்தவித அறிகுறியும் இல்லாமல் மிகச் சாதாரணமாகவே இருப்பார்கள். பின்பு திடீரென்று வேறு எதற்காவது மருத்துவமனைக்குப் போனால் ரத்தப் பரிசோதனை செய்வார்கள். அப்பொழுது தான் இவருக்கு ரத்தப் புற்றுநோய் இருக்கிறது என்பது தெரியவரும்.
1)அதிக உடல் சோர்வு 2) திடீரென்று உடல் எடை அதிகமாக குறைவது 3)காரணமில்லாமல் காய்ச்சல் அடிக்கடி வந்து போவது4) இரவில் அதிகமாக வியர்த்துக் கொட்டுவது 5) பசி இல்லாமல் போவது6) எலும்புகளிலும் மூட்டுகளிலும் வலி 7) அடிக்கடி மூக்கில் ரத்தம் கசிவது 8) மிகச் சிறிய சிவப்பு நிற ரத்தப் புள்ளிகள் உடலில் அங்கொன்றும் இங்கொன்றும் தோன்றுவது 9) மேல்மூச்சு வாங்குவது போன்ற சில அறிகுறிகள் ரத்தப் புற்றுநோய் இருப்பவர்களுக்கு வரலாம். மேலும் இவர்களது ரத்தப் பரிசோதனையில் மிக அதிக அளவில் வெள்ளை அணுக்கள் மற்றும் சிவப்பு அணுக்கள் பிளேட்லெட்டுகள் இருக்கும். சில சமயங்களில் தீய செல்களாகிய புற்றுநோய் செல்கள் கூட ரத்தப் பரிசோதனையில் தெரியவரும்.
பொதுவாக எல்லோருமே ஆறு மாதத்துக்கு ஒரு முறை அடிப்படை ரத்தப் பரிசோதனைகளை செய்து கொள்வது நல்லது. இருபது வயதுக்கு மேலுள்ள பெண்கள் அனைவரும் ஆண்டுக்கு ஒரு முறை மார்பகப் புற்றுநோயைக் கண்டுபிடிக்க செய்யப்படும் "மேம்மோகிராம்' என்கிற பரிசோதனையைக் கண்டிப்பாக செய்துகொள்ள வேண்டும். இவ்வாறாக ஒவ்வொரு பகுதி புற்றுநோயையும் கண்டுபிடிக்க பரிசோதனைகள் இப்பொழுது இருக்கின்றன.
உடலில் ஏதாவது மாற்றம் தெரிந்தால் உடனே உங்கள் குடும்ப டாக்டரைச் சந்தித்து அவர் சொல்லும் பரிசோதனைகளைச் செய்துகொண்டு சந்தேகமின்றி, சந்தோஷமாக வாழ முயற்சி செய்யுங்கள். இப்பொழுதெல்லாம் ரத்தப் புற்றுநோயால் பாதிக்கப்பட்டவர்கள் "கீமோதெரபி' என்று சொல்லக்கூடிய புதிய நவீன மருந்துகள் வந்துவிட்டதால் அதைக் கொண்டு சிகிச்சைப் பெற்று நன்கு குணமடைந்து நீண்ட காலம் வாழ்கிறார்கள். குழந்தை
களெல்லாம் கூட இப்பொழுது பூரண குணமடைந்து நீண்ட காலம் வாழ்கிறார்கள்.
ரத்தப் புற்றுநோயால் பாதிக்கப்பட்டவர்கள் உணவு விஷயத்தில் அதிக கவனம் எடுத்துக் கொள்ள வேண்டும். நன்கு சமைக்கப்படாத நன்கு வேகவைக்கப்படாத அசைவ உணவுகளையும் பச்சை முட்டைகளையும் சாப்பிடக் கூடாது. பதப்படுத்தப்படாத பால், பழம், ஐஸ், தயிர் போன்றவைகளையும் தவிர்க்க வேண்டும். ரத்தப் புற்றுநோய் சிகிச்சை எடுத்துக் கொண்டிருப்பவர்கள் மதுப்பழக்கம் இருந்தால் நிறுத்திவிடுங்கள். ஏனெனில் மதுவும் புற்றுநோய் சிகிச்சை மருந்தும் எதிரெதிர் துருவங்கள். வேலை பார்க்காது.
பொதுவாக ரத்தப் புற்றுநோய் ஒருவரிடமிருந்து அடுத்தவருக்கு பரவக்கூடியது அல்ல. வைட்டமின் சி, சத்து நிறைந்த பழங்கள், க்ரீன் டீ, காய்கறிகள், கொழுப்பு குறைவான புரதம் அதிகமான உணவுகள், மீன் வகைகள், அவரைக்காய், முழு தானியங்கள் முதலியவைகளை அதிக அளவில் இவர்கள் சாப்பிடலாம்.
நாம வியாதியோட போராடலாம்
ஆனால் விதியோட போராட முடியுமா?
முடியும். இன்றைய நவீன மருத்துவ உலகில் பல மருந்துகள் புற்றுநோயை குணப்படுத்த கிடைக்கின்றன. பயன்படுத்திக் கொள்ளுங்கள். சந்தோஷமாக வாழுங்கள்.
தொடரும் ....
தினமணி செய்திமடலைப் பெற... Newsletter
தினமணி'யை வாட்ஸ்ஆப் சேனலில் பின்தொடர... WhatsApp
தினமணியைத் தொடர: Facebook, Twitter, Instagram, Youtube, Telegram, Threads, Arattai, Google News
உடனுக்குடன் செய்திகளை அறிய தினமணி App பதிவிறக்கம் செய்யவும்.
டிரெண்டிங்



வீடியோக்கள்

தினமணி வீடியோ செய்தி...

தினமணி வீடியோ செய்தி...

தினமணி வீடியோ செய்தி...

தினமணி வீடியோ செய்தி...